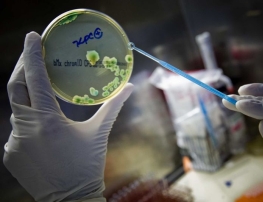

Pacientes isolados no Instituto do Câncer não estão com superbactéria, revela exame
De acordo com o Diretor Clínico do Hospital, Dr. Reginaldo Ferreira da Costa, os resultados chegaram no último domingo, 18, revelando que as bactérias presentes nos pacientes não pertenciam ao grupo do KTC
Os exames dos cinco pacientes que estavam com suspeita de terem sido contaminados no Instituto do Câncer do Ceará (ICC) por uma superbactéria apresentaram resultados negativos.
De acordo com o Diretor Clínico do Hospital, Dr. Reginaldo Ferreira da Costa, os exames chegaram no último domingo, 18, revelando que as bactérias presentes nos pacientes não pertenciam ao grupo do KTC, chamada por superbactérias.
Segundo o médico, um dos pacientes chegou a ficar isolado no tratamento por mais de 45 dias. As suspeitas da presença de superbactérias começaram a cerca de três semanas, quando dois pacientes que se tratavam de câncer morreram no ICC, ao contraírem bactérias do grupo KTC.
Saiba o que são as superbactérias (KTC)
A bactéria KPC é uma infecção hospitalar que acomete, principalmente, pacientes muito debilitados, imunodeprimidos e que passam muito tempo internados em leitos de UTI e com uso prolongado de antibióticos de amplo espectro.
Redação O POVO Online